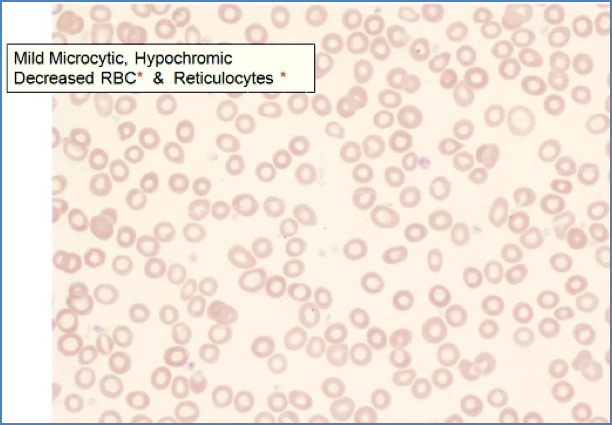
anaemia of chronic disease - Morphology

Table of Contents
Overview – Anaemia of Chronic Disease
Anaemia of chronic disease (ACD), also called anaemia of inflammation, is a common, mild-to-moderate anaemia seen in patients with chronic infections, autoimmune diseases, or malignancy. Unlike iron deficiency, ACD involves impaired iron utilisation and suppressed erythropoiesis — despite normal or increased iron stores. It is usually normocytic, though it may present as microcytic in long-standing disease. Management focuses on treating the underlying condition and addressing inflammation-driven marrow suppression.
Definition
- Anaemia caused by chronic inflammation, infection, or malignancy
- Characterised by impaired iron release, ↓ erythropoietin (EPO) production, and ↓ RBC survival
- Typically normocytic, sometimes microcytic
Aetiology
- Chronic infections: tuberculosis, osteomyelitis
- Autoimmune diseases: rheumatoid arthritis, systemic lupus erythematosus (SLE), IBD
- Malignancy: especially solid tumours and haematological cancers
Pathophysiology
- Chronic inflammation → cytokine-mediated changes:
- ↓ RBC lifespan
- ↓ EPO secretion by kidneys
- Iron sequestration in macrophages → ↓ iron availability for erythropoiesis
- Net result = functional iron deficiency, despite adequate iron stores
Morphology
- Normocytic, normochromic (typically)
- Sometimes microcytic
- Hypochromic features in chronic or advanced cases
- ↓ RBC count
- ↓ reticulocyte count
Clinical Features
- Usually mild anaemia
- Presents with general anaemia symptoms:
- Fatigue
- Pallor
- Dyspnoea on exertion
- Often overshadowed by the symptoms of the underlying chronic condition
Investigations
Blood Tests
- ↓ Hb
- ↓ Reticulocytes
Iron Studies
- ↓ Serum iron
- ↓ TIBC
- Normal or ↑ Ferritin (iron is present but trapped in macrophages)
Others
- Normal B12 and folate
- Blood film: normocytic or microcytic RBCs with hypochromia
Management
- Treat underlying disease:
- Infections, autoimmune inflammation, or malignancy
- Immunosuppression (e.g. corticosteroids) if inflammatory
- Support erythropoiesis:
- Exogenous erythropoietin (EPO) for selected cases
- Iron supplementation is not effective unless coexisting iron deficiency
Summary – Anaemia of Chronic Disease
Anaemia of chronic disease is a mild, usually normocytic anaemia driven by long-standing inflammation, impaired iron utilisation, and reduced erythropoietin response. Iron stores are preserved, but functionally unavailable. The key to management is treating the underlying condition. For a broader context, see our Blood & Haematology Overview page.